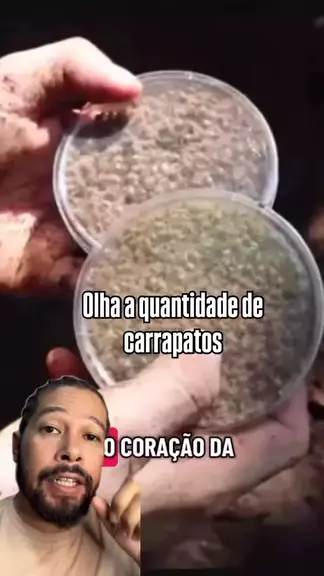

Ikuti

13

0
BioAldemir
...
Lebih banyak
Komentar
Batal
Kirim


Ikuti

2.1K

18
CasalB&W
#VivaOSãoJoãoRaiz #ChuteCampeão #seguenois #MeChamadeAmor #dancinhasdo
Lebih banyak


Ikuti

13.8K

219
Eu ciene e meu mundo animal 🐃
...
Lebih banyak